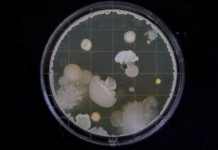
DARPA создает бактерии, умеющие улавливать взрывные устройства

Если пользователь по той или иной причине не хочет взаимодействовать со своим голосовым помощником посредством стандартных голосовых команд и голоса в целом, то у него всегда есть возможность обратиться к его функционалу посредством классического текстового набора – однако такая возможность работает обычно только тогда, когда речь идет о взаимодействии нативной среды разработки, например, между смартфоном на системе Android и помощником Google Assistant. Однако сегодня компания Amazon внедрила специальные алгоритмы поддержки взаимодействия iOS-устройств с ее умным помощником Alexa, при помощи которых пользователи могут делать абсолютно то же самое.
Иными словами, пользователи и владельцы того или иного iPhone-смартфона или стороннего iOS-устройства могут подключиться к функционалу голосового помощника Amazon Alexa и тем самым управлять им при помощи классического набора текста, избегая голосовых команд. Многим пользователям добавление такой функции может показаться чем-то не вполне понятным, поскольку речь все-таки идет о работе с голосовым помощником, однако в ряде ситуаций и случаев именно такой формат взаимодействия с ним является по-настоящему удобным.

Таким образом, пользователи и владельцы iPhone теперь могут беспроблемно подключаться к функционалу голосового помощника, тем самым беспрепятственно получая доступ к его основному и дополнительному набору возможностей, отправляя соответствующие текстовые команды. Более того, в фирменной раскладке Apple-клавиатуры на iOS-устройства даже появилась специальная кнопка, запускающая сам голосовой помощник – при помощи нее в целом можно переключаться между разными такими помощниками.
Становится очевидно, что компания Apple намеревается предложить своим пользователям нечто действительно интересное и уникальное по многим параметрам, не говоря уже о том, что тут становится намного проще ориентироваться на официальную информацию от самой компании – потому что она уже давно говорила о своем желании и решении интегрировать как можно более широкий функционал сторонних голосовых помощников в свои iOS-устройства. Таким образом, остается лишь дожидаться окончательного завершения текущей операции.